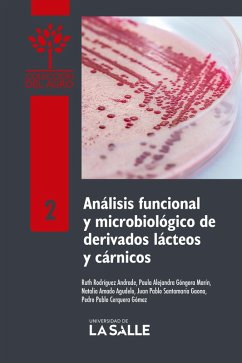

Laboratorio de microbiología para optómetras (eBook, PDF)

PAYBACK Punkte
0 °P sammeln!
Se ofrece al estudiante conceptos teóricos y prácticos aplicados directamente a la práctica optométrica, a la morfología y a la identificación de los microorganismos, así como de las manifestaciones clínicas sistémicas y oculares. Cada guía presenta las competencias que el estudiante debe alcanzar; una introducción que da el sustento teórico a la práctica; materiales, y procedimientos, paso a paso, que se realizarán en la práctica. Los resultados están enunciados en orden, con espacios para que el estudiante dibuje y escriba cada uno de los hallazgos. Finalmente, plantea al est...
Se ofrece al estudiante conceptos teóricos y prácticos aplicados directamente a la práctica optométrica, a la morfología y a la identificación de los microorganismos, así como de las manifestaciones clínicas sistémicas y oculares. Cada guía presenta las competencias que el estudiante debe alcanzar; una introducción que da el sustento teórico a la práctica; materiales, y procedimientos, paso a paso, que se realizarán en la práctica. Los resultados están enunciados en orden, con espacios para que el estudiante dibuje y escriba cada uno de los hallazgos. Finalmente, plantea al estudiante la escritura de un artículo de tipo científico con los resultados obtenidos en cada práctica, con el objeto de fomentar las competencias profesionales y habilidades en el desarrollo de proyectos de investigación.
Dieser Download kann aus rechtlichen Gründen nur mit Rechnungsadresse in A, B, BG, CY, CZ, D, DK, EW, E, FIN, F, GR, H, IRL, I, LT, L, LR, M, NL, PL, P, R, S, SLO, SK ausgeliefert werden.